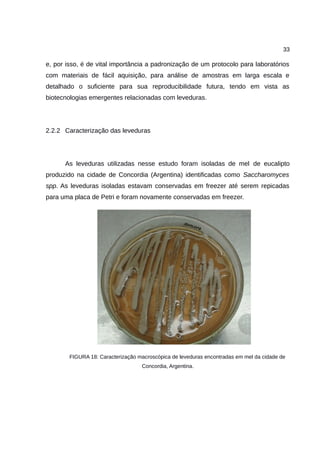
33
e, por isso, é de vital importância a padronização de um protocolo para laboratórios
com materiais de fácil aquisição, para análise de amostras em larga escala e
detalhado o suficiente para sua reproducibilidade futura, tendo em vista as
biotecnologias emergentes relacionadas com leveduras.
2.2.2 Caracterização das leveduras
As leveduras utilizadas nesse estudo foram isoladas de mel de eucalipto
produzido na cidade de Concordia (Argentina) identificadas como Saccharomyces
spp. As leveduras isoladas estavam conservadas em freezer até serem repicadas
para uma placa de Petri e foram novamente conservadas em freezer.
FIGURA 18: Caracterização macroscópica de leveduras encontradas em mel da cidade de
Concordia, Argentina.

O estudo teve como objetivo adaptar um protocolo de extração de DNA para leveduras, resultando em um método mais prático, sem fenol, que elimina contaminantes e mantém a integridade do DNA. A análise revelou uma quantidade de DNA de 1,819 μg/ml, com uma razão 260/280 considerada ideal para aplicações em PCR. O protocolo é recomendado para futuras pesquisas, especialmente na identificação molecular de microrganismos.

![77
REFERÊNCIAS
ABELHO, Manuela. Protocolos de Microbiologia Ambiental: Parte 1 – Métodos
básicos em microbiologia. Coimbra: Escola Superior Agrária Instituto Politécnico de
Coimbra, 2013.
AUSUBEL, Frederick M. et al. Current Protocols in Molecular Biology. John Wiley
& Sons Inc, 2003
BENAVENT, J. L. Aleixandre; ESPARZA, M. J. García. Prácticas de procesos de
elaboración y conservación de alimentos. [s.i.]: Universidad Politecnica de
Valencia, 1996.
BETTS, Roy. Microbial update: yeasts and moulds. International Food
Hygiene.Disponível em:
<https://www.thermoscientific.com/content/dam/tfs/SDG/MBD/MBD
Documents/Catalogs & Brochures/Microbiology/Food/International-Food-Hygiene-
Vol24-No4-Yeast-Moulds.pdf>. Acesso em: 01 abr. 16.](https://image.slidesharecdn.com/relatriotcnicofinaldepesquisajasminecostajardimifsc-160617014934/85/Aperfeicoamento-de-Protocolo-para-Extracao-de-DNA-de-Leveduras-com-Metodo-CTAB-78-320.jpg)
![78
ODA; LEILA; ÁVILA et al. Biossegurança em Laboratórios de Saúde Pública.
Brasília: Ministério da Saúde, 1998.
BOTSTEIN, D.; FINK, G. R.. Yeast: An Experimental Organism for 21st Century
Biology. Genetics, [s.l.], v. 189, n. 3, p.695-704, 1 nov. 2011. Genetics Society of
America. http://dx.doi.org/10.1534/genetics.111.130765.
GABRIEL DORADO PÉREZ. Purificación y análisis de DNA cromosómico
bacteriano. Prácticas Generales de Bioquímica y Biología Molecular, Córdoba, v.
7, n. 43. Disponível em: <http://www.uco.es/dptos/bioquimica-biol-mol/pdfs/43
PURIFICACIÓN ANÁLISIS DNA BACTERIANO.pdf>. Acesso em: 02 abr. 2016.
GERHARDT, Tatiana Engel; SILVEIRA, Denise Tolfo (Org.). Métodos de pesquisa.
Porto Alegre: Ufrgs, 2009.
LEE, Christopher K. et al. Factors affecting chemical-based purification of DNA from
Saccharomyces cerevisiae. Yeast, [s.l.], v. 29, n. 2, p.73-80, 2 dez. 2011. Disponível
em: <http://dx.doi.org/10.1002/yea.1918>. Acesso em: 25 fev. 2015.](https://image.slidesharecdn.com/relatriotcnicofinaldepesquisajasminecostajardimifsc-160617014934/85/Aperfeicoamento-de-Protocolo-para-Extracao-de-DNA-de-Leveduras-com-Metodo-CTAB-79-320.jpg)
![79
LÕOKE, Marko; KRISTJUHAN, Kersti; KRISTJUHAN, Arnold. Extraction of genomic
DNA from yeasts for PCR-based applications. BioTechniques: The International
Journal of Life Science Methods, [s.i.], v. 50, n. 5, p.325-328, 2011.
MINAS, Konstantinos et al. Optimization of a high-throughput CTAB-based protocol
for the extraction of qPCR-grade DNA from rumen fluid, plant and bacterial pure
cultures. Fems Microbiol Lett, [s.l.], v. 325, n. 2, p.162-169, 24 out. 2011. Disponível
em: <http://dx.doi.org/10.1111/j.1574-6968.2011.02424.x>. Acesso em: 07 mar.
2016.
NIELSEN, J.. Yeast cell factories on the horizon. Science, [s.l.], v. 349, n. 6252,
p.1050-1051, 3 set. 2015. American Association for the Advancement of Science
(AAAS). http://dx.doi.org/10.1126/science.aad2081.
PINCUS, D. H.; ORENGA, S.; CHATELLIER, S.. Yeast identification – past, present,
and future methods. Med Mycol, [s.l.], v. 45, n. 2, p.97-121, jan. 2007. Disponível
em: <http://dx.doi.org/10.1080/13693780601059936>. Acesso em: 20 mar. 2016.
PONZZES, Camila Munique Paula Baltar Silva de et al. CARACTERIZAÇÃO DO
FATOR KILLER EM LEVEDURAS SELVAGENS ISOLADAS DURANTE O
PROCESSO FERMENTATIVO DE VINHOS TROPICAIS NO BRASIL. [s.i.]: Ufmg,
2007. Disponível em:
<https://www.alice.cnptia.embrapa.br/alice/bitstream/doc/160353/1/OPB1544.pdf>.
Acesso em: 19 abr. 2016.](https://image.slidesharecdn.com/relatriotcnicofinaldepesquisajasminecostajardimifsc-160617014934/85/Aperfeicoamento-de-Protocolo-para-Extracao-de-DNA-de-Leveduras-com-Metodo-CTAB-80-320.jpg)

